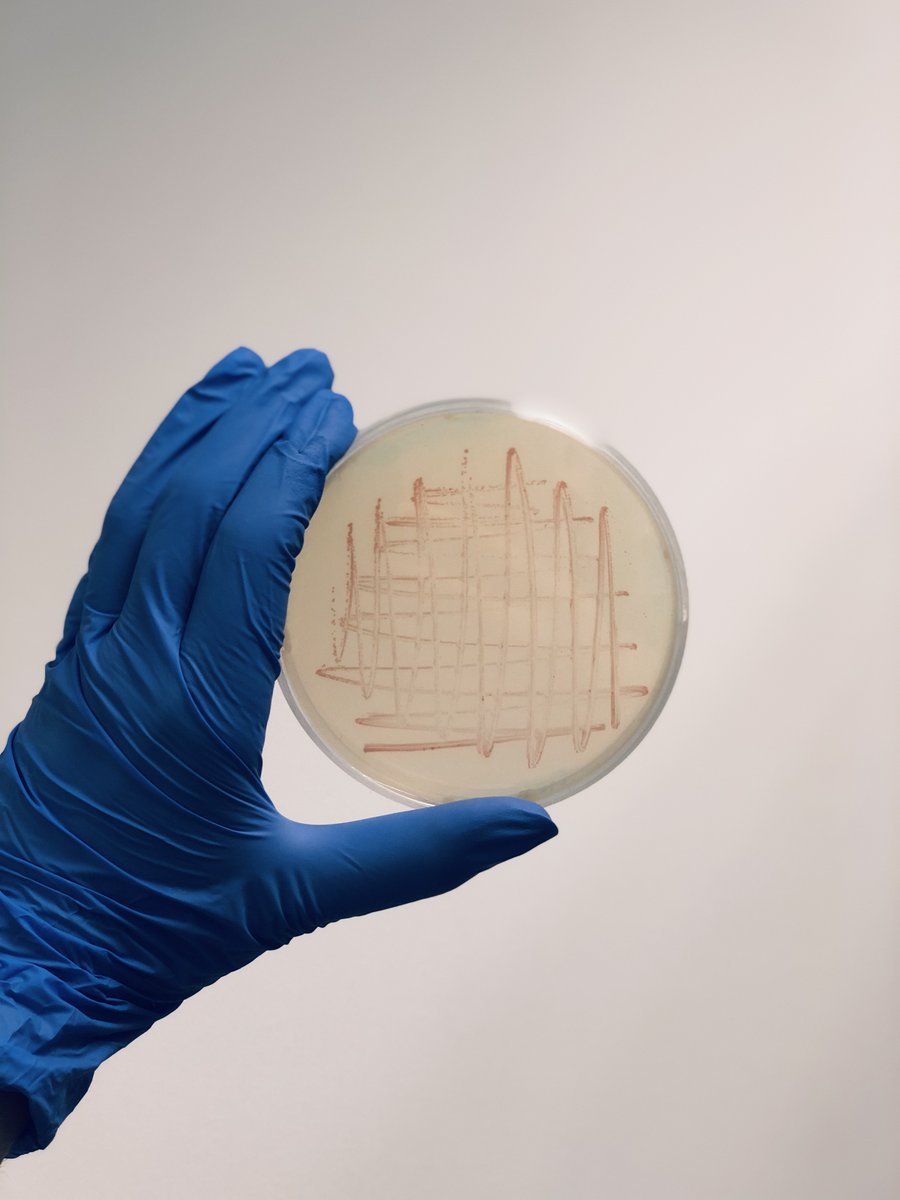
¿Sabíais que hoy se celebra el Día Internacional de los Microorganismos? 📆 🦠Este día se creó para dar a conocer el papel tan importante que tienen en nuestros ecosistemas 🌍.
En IDForest utilizamos bacterias 🧫 para promover el crecimiento de las plantas 🌾 de forma ecológica.

María Hernández
@mariaforestal
ID: 247435318
04-02-2011 19:59:30
115 Tweet
136 Followers
152 Following

Durante estos días, personal de Micología Aplicada de UVa Campus de Palencia e IDForest estarán en #Etiopía impartiendo cursos de #formación en #micología a científicos, gestores y población rural.


Pablo Martín-Pinto (iuFOR UVa-INIA, Gabinete de Comunicación Universidad de Valladolid) e Iván Franco (IDForest) visitan junto a Tatek Dejene y Wubalem Tadesse de eefri-ethiopia la sede de la AECID en #AddisAbeba, para hablar de los avances del proyecto. #Cooperación #Micología #Hongos #DesarrolloSostenible



Somos centro privado de referencia, reconocido por la Junta de Castilla y León para el análisis de la planta #micorrizada que se utilizará en las plantaciones acogidas a las ayudas para el fomento de especies #forestales de alto valor cofinanciadas por la REDR de Desarrollo Rural #IDForest


La micóloga que investiga cómo cultivar boletus en suelo pobre: "Hay mucho interés en producirlo" m.eldiario.es/_38d2496f vía elDiario.es



Día de la mujer y la niña en la ciencia 2020. Visibilizando el trabajo para eliminar estereotipos. Día Mujer y Ciencia 📷 SoyForestal IDForest iuFOR UVa-INIA


ETSIIAA Palencia UVa Campus de Palencia SoyForestal Gabinete de Comunicación Universidad de Valladolid Parque Científico UVa UVadivulga INIA-CSIC Ruth Martín 19 - María Hernández @mariaforestal Doctora Ingeniera de Montes, de idforest @idforest 📸 @soyforestal #MujeryCiencia #somosIUFOR #SoyForestal #11F2020 #DiadelaMujerylaNiñaenlaCiencia #forestry #womeninforestry #mujeresforestales #11F



¡Ya tenemos nuestros sellos de cálculo de huella de carbono, expedidos por el Ministerio de Transición Ecológica, que nos ha calculado ECM Ingeniería Ambiental! ¡Gracias compañer@s! #carbonfootprint #huelladecarbono #cop25 #IDForest Transición Ecológica y Reto Demográfico


Es una pena que nos estemos perdiendo un año fenomenal de Morchella esculenta. Ahora seguiremos trabajando para potenciar su producción en el marco del proyecto de cooperación internacional en Etiopía de la Alex Pryazhnikov, encaminado al desarrollo de este producto #IDForest SUSTFUNGI_ET



Team of Mycelio inoculating new batches of substrate with spawn of different mushroom varieties. Important progress in the Mycoeconomy part of our LIFE MycoRestore project, co-financed by the EU's LIFE Programme pic.x.com/xKyz20DSdE


Last Saturday we went to Tavertet (Barcelona) to give a log fungal inoculation workshop with cellio alison dias, SocialForest and Дарья Дегтярева within the LIFE MYCORESTORE project. It was great! #RevalorizandoProductosForestales #IDForest #LIFE #Fungi #Biotech #biotecnologiaforestal





😃😃 Hoy hemos recibido la visita de investigadores del Instituto Forestal acompañados por celia e Irene Ruano del iuFOR UVa-INIA 👏🏼👏🏼